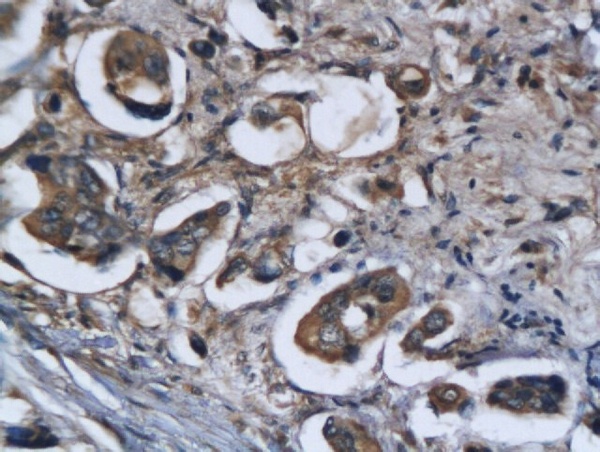
Formalin-fixed and paraffin embedded human colorectal cancer labeled with Anti Legumain Polyclonal Antibody, Unconjugated (bs-3907R) followed by conjugation to the secondary antibody and DAB staining Formalin-fixed and paraffin embedded human colorectal cancer labeled with Anti Legumain Polyclonal Antibody, Unconjugated (bs-3907R) followed by conjugation to the secondary antibody and DAB staining
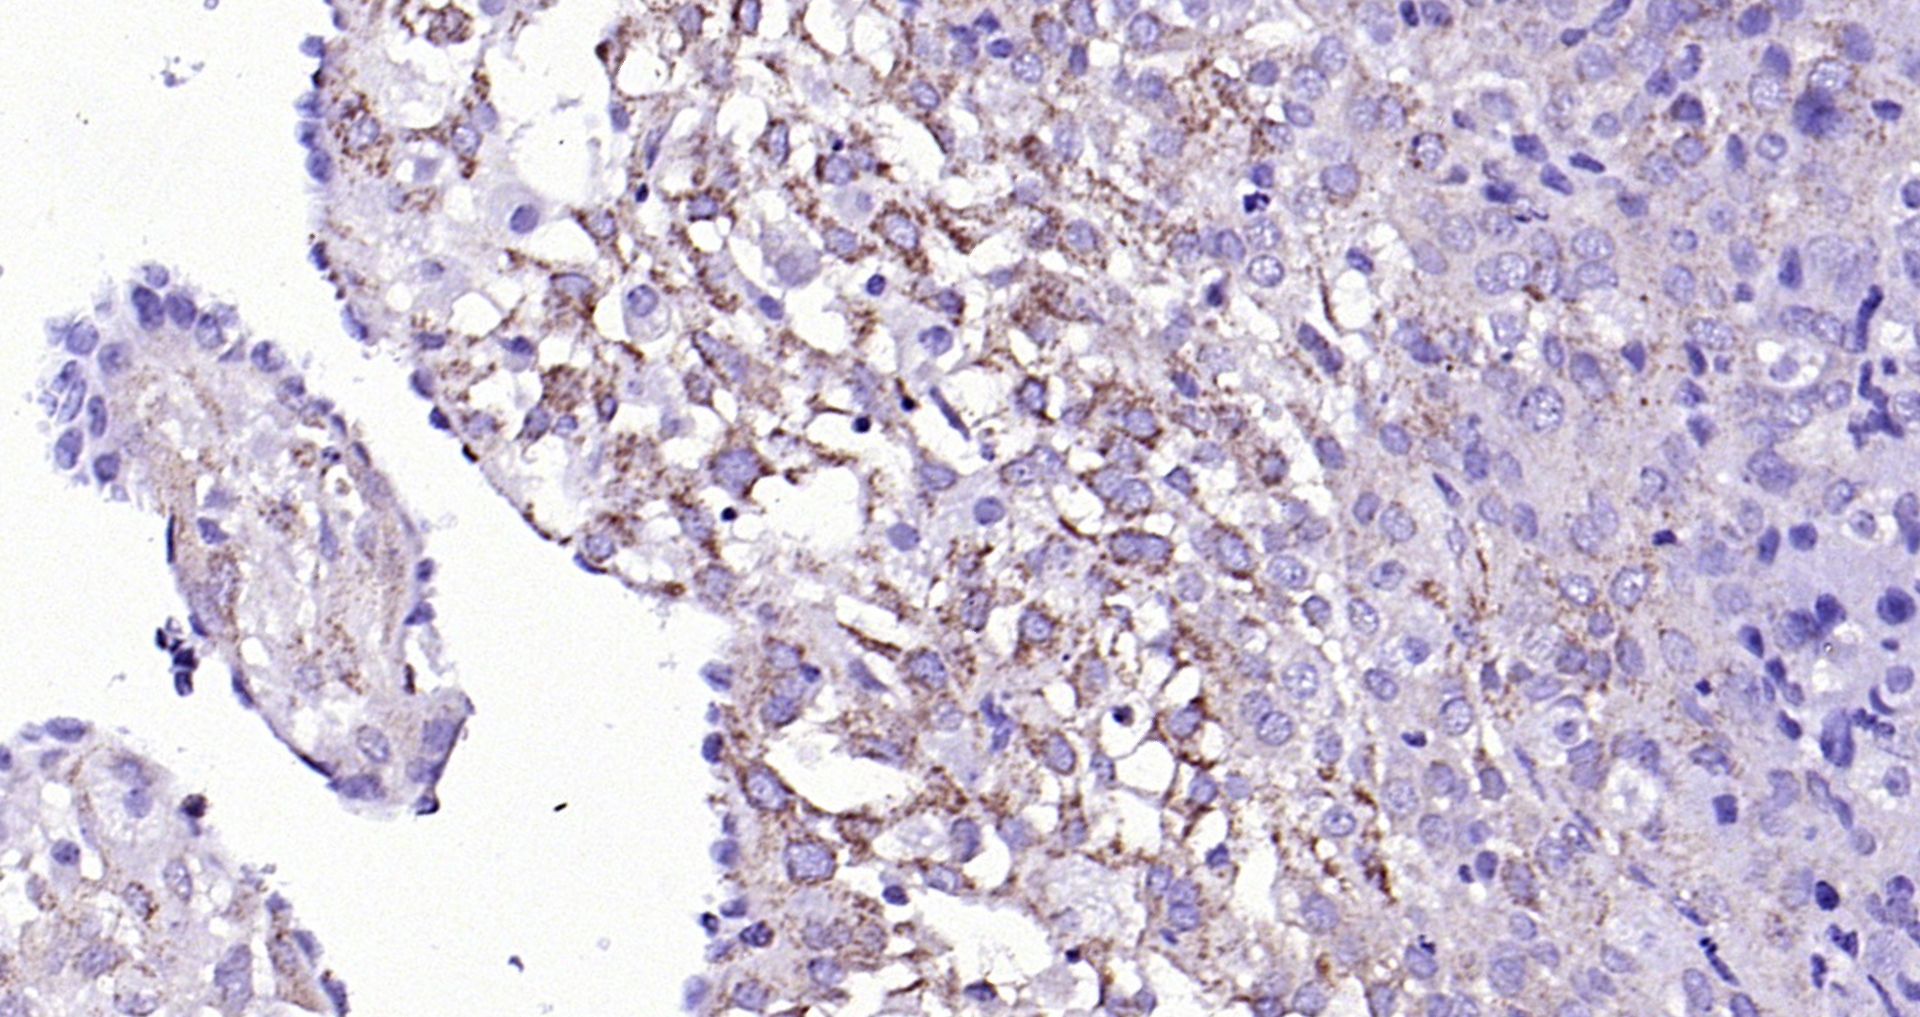
Paraformaldehyde-fixed, paraffin embedded (mouse placenta); Antigen retrieval by boiling in sodium citrate buffer (pH6.0) for 15min; Block endogenous peroxidase by 3% hydrogen peroxide for 20 minutes; Blocking buffer (normal goat serum) at 37°C for 30min; Antibody incubation with (Legumain) Polyclonal Antibody, Unconjugated (bs-3907R) at 1:200 overnight at 4°C, followed by operating according to SP Kit(Rabbit) (sp-0023) instructionsand DAB staining. Paraformaldehyde-fixed, paraffin embedded (mouse placenta); Antigen retrieval by boiling in sodium citrate buffer (pH6.0) for 15min; Block endogenous peroxidase by 3% hydrogen peroxide for 20 minutes; Blocking buffer (normal goat serum) at 37°C for 30min; Antibody incubation with (Legumain) Polyclonal Antibody, Unconjugated (bs-3907R) at 1:200 overnight at 4°C, followed by operating according to SP Kit(Rabbit) (sp-0023) instructionsand DAB staining.

Moues kidney lysates probed with Legumain Polyclonal Antibody, unconjugated (bs-3907R) at 1:300 overnight at 4°C followed by a conjugated secondary antibody at 1:10000 for 90 minutes at 37°C.
Legumain Polyclonal Antibody
BS-3907R
ApplicationsFlow Cytometry, ImmunoFluorescence, Western Blot, ImmunoHistoChemistry, ImmunoHistoChemistry Frozen, ImmunoHistoChemistry Paraffin
Product group Antibodies
ReactivityBovine, Canine, Equine, Human, Mouse, Rat
TargetLGMN
Overview
- SupplierBioss
- Product NameLegumain Polyclonal Antibody
- Delivery Days Customer16
- ApplicationsFlow Cytometry, ImmunoFluorescence, Western Blot, ImmunoHistoChemistry, ImmunoHistoChemistry Frozen, ImmunoHistoChemistry Paraffin
- Applications SupplierWB(WB=1:500-2000), IHC-P(IHC-P=1:100-500), IHC-F(IHC-F=1:100-500), IF(IF=1:100-500), FCM(FCM=3ug/Test)
- CertificationResearch Use Only
- ClonalityPolyclonal
- Concentration1 ug/ul
- ConjugateUnconjugated
- Gene ID5641
- Target nameLGMN
- Target descriptionlegumain
- Target synonymsAEP, LGMN1, PRSC1, legumain, asparaginyl endopeptidase, cysteine protease 1, protease, cysteine 1, protease, cysteine, 1 (legumain)
- HostRabbit
- IsotypeIgG
- Protein IDQ99538
- Protein NameLegumain
- ReactivityBovine, Canine, Equine, Human, Mouse, Rat
- Storage Instruction-20°C
- UNSPSC41116161

![WB analysis of human placental tissue lysate using GTX53080 Legumain antibody [46I3].](https://www.genetex.com/upload/website/prouct_img/normal/GTX53080/GTX53080_20191119_WB_w_23060900_391.webp)